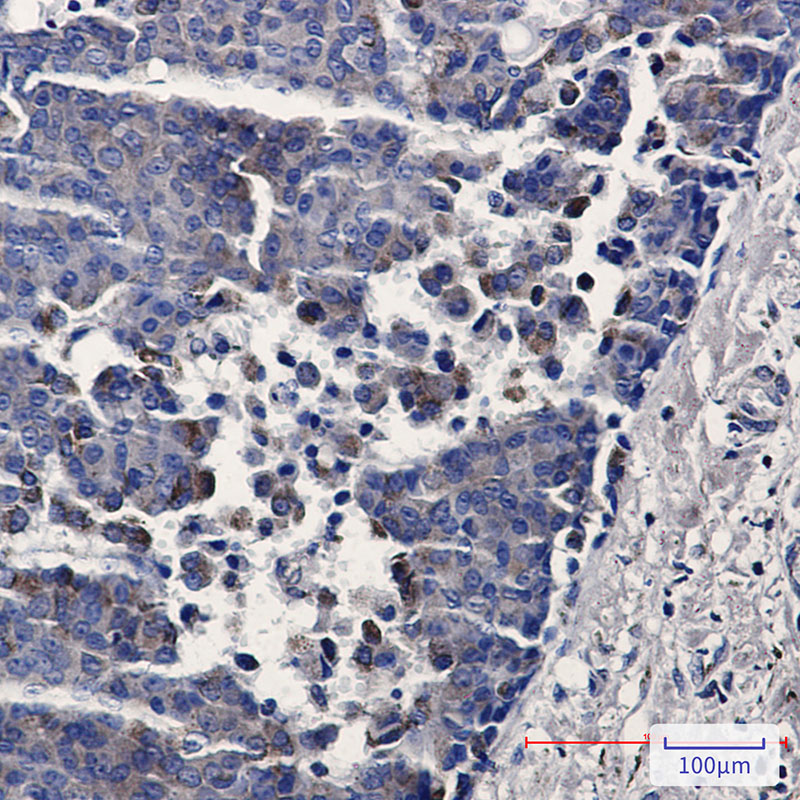

-
分类: 科研抗体货号: P20932别名: Transcription factor SOX-10应用: WB反应种属: Human,Rat
-
分类: 科研抗体货号: P20911别名: DNA mismatch repair gene; DNA mismatch repair protein PMS2; HNPCC4; PMS1 protein homolog 2应用: WB,IP反应种属: Human
-
分类: 科研抗体货号: P20890别名: bHLHe74; mNRC 1; NCoA 1; RIP160; SRC 1应用: WB,IP,IHC反应种属: Human
-
分类: 科研抗体货号: P20910别名: TFRC; Transferrin receptor protein 1; TR; TfR; TfR1; Trfr; T9; p90; CD71应用: WB,IP反应种属: Human
-
分类: 科研抗体货号: P20889别名: AGS1; AGS5; CRV; DNase III; DRN3; HERNS; TREX1应用: WB,IHC,IF反应种属: Human
-
分类: 科研抗体货号: P20931别名: glypican应用: WB,IF反应种属: Human
-
分类: 科研抗体货号: P20909别名: A2MR; alpha 2MR; Alpha 2 macroglobulin receptor; CD91; APR; LRP1; LRP85; TGFBR5应用: WB,IP,IHC,IF反应种属: Human,Mouse,Rat
-
分类: 科研抗体货号: P20921别名: GFAP; FLJ45472; cb345; ALXDRD应用: WB,IHC,IF反应种属: Human,Rat
-
分类: 科研抗体货号: P20930别名: Glutamate decarboxylase 1; 67 kDa glutamic acid decarboxylase; GAD 67; GAD1; GAD; GAD67应用: WB,IP反应种属: Human
-
分类: 科研抗体货号: P20908别名: KRT16; KRT16A; Keratin; type I cytoskeletal 16; Cytokeratin-16; CK-16; Keratin-16; K16应用: WB,IHC反应种属: Human

鄂公网安备42018502007531号
鄂公网安备42018502007531号

